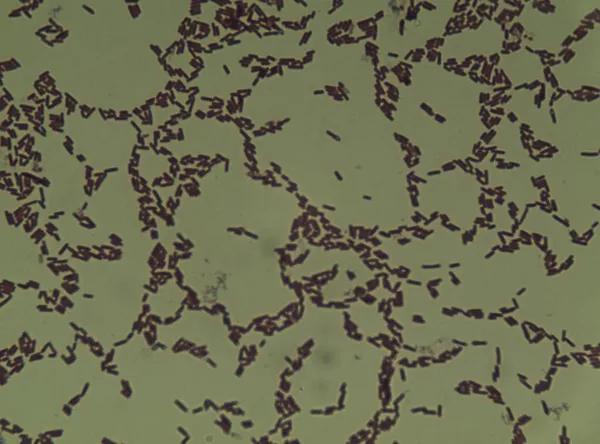
水产养殖中，不同有益菌有不同作用！菌类到底怎么用？

微生态制剂在水产中的应用越来越广泛,EM菌,乳酸菌,光合细菌,酵母菌等各种微生物到底如何应用,养殖朋友不一定全面了解,今天小编就和大家聊一聊水产中的有益菌
1、什么是芽孢杆菌
芽孢杆菌(Bacillus),细菌的一科,能形成芽孢(内生孢子)的杆菌或球菌。它们对外界有害因子抵抗力强,分布广,存在于土壤、水、空气以及动物肠道等处。芽孢杆菌(bacillus)杆菌科的一属细菌。
芽孢杆菌:芽孢杆菌菌体生长过程中产生的枯草菌素、多粘菌素、制霉菌素、短杆菌肽等活性物质,这些活性物质对致病菌或内源性感染的条件致病菌有明显的抑制作用。芽孢杆菌菌体自身合成α-淀粉酶、蛋白酶、脂肪酶、纤维素酶等酶类,在消化道中与动物体(人体)内的消化酶类一同发挥作用。.能合成维生素B1、B2、B6、烟酸等多种B族维生素,提高动物体(人体)内干扰素和巨噬细胞的活性。
芽孢杆菌对水产中的弧菌、大肠杆菌和杆状病毒等有害微生物有很强的抑制作用,有效预防水产动物肠炎,烂鳃等疾病。分泌大量几丁质酶的功能,几丁质酶可分解病原真菌的细胞壁而抑制真菌病害,分解养殖池中的有毒有害物质,净化水质;分解池中残饵、粪便、有机物等,具有很强的清理水中垃圾小颗粒的作用;
芽孢杆菌能够改善有害蓝藻泛溢造成的水质浑浊问题,水质由浑变清,具有很强的净化水质功能,具有较强的蛋白酶、脂肪酶、淀粉酶的活性,促进饲料中营养素降解,使水产类动物对饲料的吸收利用更加充分;
芽孢杆菌可以减少对虾病害发生,可以大大提高对虾产量,从而提高经济效益,生物环保,刺激水产动物免疫器官的发育,增强机体免疫力;减少对虾病害发生,明显提高对虾产量,从而提高经济效益,净化水质,无污染,无残留。
各种芽孢杆菌的作用:
地衣芽孢杆菌
产酶、分解
解淀粉芽孢杆菌
产酶、分解
巨大芽孢杆菌
降解氨氮、亚硝酸盐
枯草芽孢杆菌
分解大分子有机物,降解氨氮、亚硝酸,抗菌素

使用方法:
1、菌:红糖:水;按0.5:1.5:25左右的比例浸泡两个小时以上,浸泡时用小的气泵曝气更佳。
1、耗养,使用时间是晴天上午9到11点,开水使用,使用后打开增氧机或撒增氧片。
2、使用温度是25℃以上为宜,水温低,效果不理想
3、芽孢杆菌再池塘中存在有机氮(氨基酸)、氨态氮、亚硝态氮时先利用有机氮,再利用氨态氮,最后利用亚硝态氮。
2、光合细菌:
光合细菌是地球上出现最早、自然界中普遍存在、具有原始光能合成体系的原核生物,是在厌氧条件下进行不放氧光合作用的细菌的总称,是一类没有形成芽孢能力的革兰氏阴性菌,是一类以光作为能源、能在厌氧光照或好氧黑暗条件下利用自然界中的有机物、硫化物、氨等作为供氢体兼碳源进行光合作用的微生物。

其特点如下:
1、以太阳为能量,自养型
1、厌氧菌
2、利用水体中的有机物做碳源,供氢体
3、利用水环境中的溶解氮(氨氮,硝酸盐,亚硝酸盐等)
4、可以作为饵料给浮游动物,也可以作为幼苗的食物
5、碱性物质,酸性不要用
作用:1、降低有害物质,降解水体中的氨氮,动物排泄物,亚硝酸,二氧化硫等有害物质,来合生自己的有机物
2、增氧效果,光合细菌生长繁殖时,能通过吸收水体中的耗养物质,间接增氧
3、饵料生物
4、维持水体微*天升**平衡
5、饲料添加剂
6、预防病害
3、酵母菌:酵母菌是一种单细胞真菌,酵母菌在有氧和无养环境中都能生长,碱性厌氧菌
1、有氧的条件下把糖类分解成二氧化碳
2、缺氧的条件下酵母菌把糖分解成酒精和二氧化碳
作用
1、节约饲料,降低饲料成本,酵母菌具有糖化饲料的作用,大量的饲料被转化成有机的酵母成分,不但营养成分增加,而且酵母中的酶更能促进动物的消化吸收,进而达到节省饲料,降低生产成本的目的。可维护胃肠道微生态平衡,选择性促进肠道有益菌群的增值,抑制有害菌。
2、提高动物的生产性能:酵母有含大量的生物蛋白,丰富的B族维生素,氨基酸、核算、甲壳素、多聚糖、葡萄糖、葡萄糖、是鱼虾的优良营养物质。
4、乳酸菌:
乳酸菌:乳酸菌是一类能利用可发酵碳水化合物产生大量乳酸的细菌的通称。革兰氏阳性菌。不耗氧
1、兼具需养和厌氧的性能,有氧或无氧条件可以分解水中残儿产生的有机物质,从而形成有利于有益菌繁殖生长的适宜的环境,改善生物体内的微生物种群,能降低水体及稳定水体酸碱度,维持水体的酸碱平衡。乳酸菌可以抑制有害藻类的生长,比如蓝藻甲藻,都喜欢高的PH,可以泼洒乳酸菌来抑制蓝藻的生长。
2、乳酸菌降解碳水化合物形成乳酸来降低动物肠道内的PH值,从而抑制肠道内部耐酸的厌氧病原菌生长和繁殖,并增强对动物的免疫力和抗病能力。
3、为宿主提供可医用的必须氨基酸和各种微生物,增强动物的营养代谢,直接促进生长。
4、乳酸菌的代谢产物乳酸及其他有机酸,能够有助于钙铁微生素的吸收
5、代谢产物中的酸性物质,乳酸菌素,过氧化氢能抑制病原菌的生长,可以有效的一直哈维氏弧菌,溶藻弧菌,副溶血弧菌等多种弧菌引起的对虾疾病。
使用方法,乳酸菌生长的PH再8.2以上的池塘采取拌料的方式最佳,建议全池泼洒。
阴雨天也可以使用
养殖户在投喂时,可以搅拌添加乳酸菌投喂,不仅能促进消化,有益肠道健康,提高饵料利用率,降低饵料成本;还能一定程度抑制有害细菌滋生。
【超浓缩乳酸菌】超浓乳酸菌 净水调水调节肠道促进幼苗生长饲吸收抑菌水产鱼药虾蟹养殖动保帮
¥15.9
购买
5、EM菌
一种混合菌,一般包括芽孢杆菌,光合细菌,酵母菌,乳酸菌等等有益菌类。
效果:
1、降低发病率,死亡率
2、促进生长发育,增值,增加产量,乳酸菌促进消化吸收
3、改善肉质(乳酸菌)
4、净化水质,改善环境,延长换水间隔
5、减少抗生素的使用。
水产中的有益菌在应用的过程中需要搭配使用,交替使用,不要使用单一的产品,使用过程中每亩地可以添加2斤红糖,这样才能使效果达到最大效果。